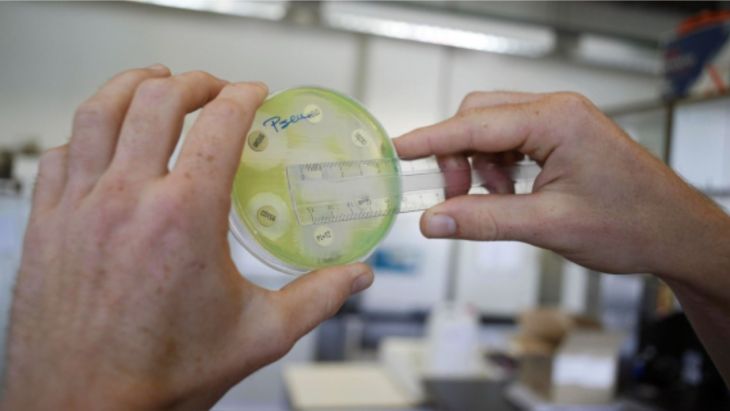

Más de 1,2 millones de personas murieron en 2019 como consecuencia directa de infecciones bacterianas resistentes a los antibióticos, según la estimación más completa hasta la fecha del impacto mundial de la resistencia a los antimicrobianos (RAM).
En concreto, este análisis de 204 países y territorios, publicado en la revista científica The Lancet, muestra que la RAM fue directamente responsable de un estimado de 1,27 millones de muertes en todo el mundo, y se asoció con unas 4,95 millones de muertes en 2019. Mientras tanto, se calcula que el VIH/sida y la malaria causaron 860 mil y 640 mil muertes, respectivamente, en 2019.
Así, el informe revela que la RAM es ahora una de las principales causas de muerte en todo el mundo, más que el VIH/sida o la malaria. Además, señala que muchos cientos de miles de muertes se producen ahora debido a infecciones comunes, antes tratables (como las infecciones de las vías respiratorias bajas y del torrente sanguíneo), porque las bacterias que las causan se han vuelto resistentes al tratamiento.
El informe subraya la necesidad "urgente" de intensificar la lucha contra la RAM, y expone "medidas inmediatas que ayudarán a salvar vidas y proteger los sistemas sanitarios", como la optimización del uso de los antibióticos existentes, la adopción de mayores medidas para vigilar y controlar las infecciones y la aportación de más fondos para desarrollar nuevos antibióticos y tratamientos.
También te puede interesar: Desarrollan pinturas capaces de inhibir virus y bacterias en Perú
"Estos nuevos datos revelan la verdadera magnitud de la resistencia a los antimicrobianos en todo el mundo, y son una clara señal de que debemos actuar ya para combatir la amenaza. Las estimaciones anteriores preveían 10 millones de muertes anuales por resistencia a los antimicrobianos para 2050, pero ahora sabemos con certeza que ya estamos mucho más cerca de esa cifra de lo que pensábamos. Tenemos que aprovechar estos datos para corregir el rumbo e impulsar la innovación si queremos mantenernos a la cabeza en la carrera contra la resistencia a los antimicrobianos", ha comentado el coautor del estudio, el profesor Chris Murray, del Instituto de Métrica y Evaluación de la Salud de la Universidad de Washington (Estados Unidos).
Este nuevo informe estima las muertes relacionadas con 23 patógenos y 88 combinaciones patógeno-fármaco en 204 países y territorios en 2019. Se utilizaron modelos estadísticos para producir estimaciones del impacto de la RAM en todos los lugares, incluidos los que no tienen datos, utilizando 471 millones de registros individuales obtenidos de revisiones sistemáticas de la literatura, sistemas hospitalarios, sistemas de vigilancia y otras fuentes de datos.
La carga de la enfermedad se estimó de dos maneras: las muertes causadas directamente por la RAM (es decir, las muertes que no se habrían producido si las infecciones hubieran sido susceptibles a los medicamentos y, por tanto, más tratables), y las muertes asociadas a la RAM (es decir, cuando una infección resistente a los medicamentos estaba implicada en las muertes, pero la resistencia en sí misma puede haber sido o no la causa directa). Las muertes causadas y asociadas a la RAM se calcularon para 204 países y territorios y se comunicaron para 21 regiones mundiales y siete suprarregiones.
¿Cuáles son las bacterias resistentes que más matan?
La farmacorresistencia en las infecciones respiratorias bajas, como la neumonía, tuvo el mayor impacto en la carga de enfermedad de la RAM, causando más de 400 mil muertes y asociada a más de 1,5 millones de muertes.
La farmacorresistencia en las infecciones del torrente sanguíneo (que pueden dar lugar a una afección potencialmente mortal, la sepsis) causó alrededor de 370 mil muertes y se asoció a casi 1,5 millones de fallecimientos. La farmacorresistencia en las infecciones intraabdominales, causadas habitualmente por la apendicitis, provocó directamente unas 210 mil muertes y se asoció a unas 800 mil.
El informe advierte de que aunque la RAM supone una amenaza para personas de todas las edades, los niños pequeños "corren un riesgo especialmente elevado, ya que una de cada cinco muertes atribuibles a la RAM se produce en niños menores de cinco años".
Las muertes causadas directamente por la RAM se estimaron como las más altas en el África subsahariana y en el sur de Asia, con 24 muertes por cada 100 mil habitantes y 22 muertes por cada 100 mil habitantes, respectivamente.
No dejes pasar: Advierte OPS sobre excesivo uso de antibióticos en pandemia
La RAM se asoció a 99 muertes por cada 100 mil habitantes en el África subsahariana y a 77 muertes por cada 100 mil habitantes en el sur de Asia. En los países de ingresos altos, la RAM provocó directamente 13 muertes por cada 100 mil habitantes y se asoció a 56 muertes por cada 100 mil habitantes.
De los 23 patógenos estudiados, la farmacorresistencia de seis de ellos (E. coli, S. aureus, K. pneumoniae, S. pneumoniae, A. baumannii y P. aeruginosa) provocó directamente 929 mil muertes y se asoció a 3,57 millones. Una combinación patógeno-fármaco (S. aureus resistente a la meticilina, o SARM) causó directamente más de 100 mil muertes en 2019, mientras que otros seis causaron cada uno entre 50 mil y 100 mil muertes.
En todos los patógenos, la resistencia a dos clases de antibióticos que suelen considerarse la primera línea de defensa contra las infecciones graves (las fluoroquinolonas y los antibióticos betalactámicos) fue la causa de más del 70 por ciento de las muertes causadas por la RAM.
El impacto sanitario de los patógenos varió mucho según el lugar, ya que las muertes atribuibles a la RAM en el África subsahariana fueron causadas con mayor frecuencia por S. pneumonia (16 por ciento de las muertes) o K. pneumonia (20 por ciento), mientras que alrededor de la mitad de las muertes atribuibles a la RAM en los países de ingresos altos fueron causadas por S. aureus (26 por ciento) o E. coli (23 por ciento).
Edición: Emilio Gómez

El plan probablemente provocará un enfrentamiento con la asociación de jugadores
Ap
Experimento con ratones con el uso de proteínas FGF2 y BMP2 resultó exitoso
La Jornada
Hospitales tienen dificultades para hacer frente a las temperaturas y al aumento de llamadas de emergencia
Afp
La tradición oral o una nota testimonial como recurso histórico y social
Felipe Escalante Tió